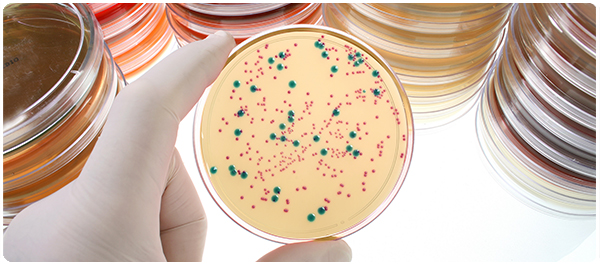

on
เรื้อน (ตอนที่ 3)
26 มกราคม 2016
โรคเรื้อนเป็นโรคที่เกิดมากในหลายประเทศทั่วโลกที่อยู่ในเขตอบอุ่น (Temperate) เขตร้อน (Tropical) และค่อนข้างร้อน (Subtropical) ในสหรัฐอเมริกามีการพบผู้ป่วยโรคเรื้อนปีละ 100 ราย ซึ่งส่วนใหญ่อาศัยอยู่ทางใต้ แคลิฟอร์เนีย ฮาวาย และตามหมู่เกาะ
โรคเรื้อนมี 2 ชนิด คือ
1. โรคเรื้อนทูเบอร์คูลอยด์ (Tuberculoid) - มีการติดเชื้อในบริเวณจำกัดและมีจำนวนเชื้อแบคทีเรียที่น้อย
2. โรคเรื้อนเลโพรมาทัส (Lepromatous) – มีการกระจายของเซลล์ที่ติดเชื้อแบคทีเรียในวงกว้างและในจำนวนที่มากกว่า
โดยทั้ง 2 ชนิด ก่อให้เกิดความเจ็บปวดต่อผิวหนัง อย่างไรก็ดี โรคเรื้อนเลโพรมาทัสจะมีอาการรุนแรงมากกว่า และเป็นก้อนนูน (Nodules) ขนาดใหญ่กว่า
ส่วนใหญ่อาการของโรคเรื้อนจะมีผลกระทบต่อผิวหนัง เส้นประสาท และเยื่อเมือกบุผิว (Mucous membranes) แต่เนื่องจากโรคเรื้อนมีระยะฟักตัวที่นานและอาการจะค่อยๆ ปรากฏ ดังนั้นการสังเกตอาการเบื้องต้นก็คือ การที่ผิวหนังเป็นตุ่มนูนหรือปวด ขนคิ้วร่วง และชาบริเวณผิวหนังที่เป็น ส่วนอาการอื่นๆ ได้แก่
- ผิวหนังบริเวณที่เป็น (Skin lesions) จะมีสีจางมากกว่าผิวหนังปกติ
- ผิวหนังส่วนนั้นจะแห้งและหนา
- ผิวหนังส่วนนั้นจะมีการรับรู้ความรู้สึกที่น้อยลงจากการสัมผัส ความร้อน หรือความเจ็บปวด
- ผิวหนังส่วนนั้นจะไม่หายแม้ว่าจะเป็นเวลานานหลายสัปดาห์หรือหลายเดือนก็ตาม
- กล้ามเนื้ออ่อนแรง (Muscle weakness)
- มือ แขน เท้า ขา ชาหรือไร้ความรู้สึก
- เลือดกำเดาไหล (Nosebleeds)
- เป็นแผลเปื่อยที่ฝ่าเท้า (Ulcers on the soles of feet)
การวินิจฉัยโรคได้เร็วเป็นสิ่งสำคัญ เพราะการรักษาแต่เนิ่นๆ จะสามารถลดความเสียหาย ป้องกันการแพร่เชื้อไปยังผู้อื่น และทำให้ผู้ป่วยสามารถใช้ชีวิตที่ปกติได้
การวินิจฉัยว่าเป็นโรคเรื้อนหรือไม่ สามารถทำได้โดย
- การทดสอบเลโปรมินทางผิวหนัง (Lepromin skin test) เพื่อหาว่าเป็นโรคเรื้อนชนิดไหน
- การตัดชิ้นเนื้อบริเวณที่เป็นไปตรวจ (Skin lesion biopsy)
- การเก็บตัวอย่างขุยที่ผิวหนังไปตรวจ (Skin scraping examination)
แหล่งข้อมูล
1. Hansen's disease (Leprosy). [2015, January 25].
2. Leprosy[2015, January 25].
3. Is Leprosy (Hansen's Disease) Contagious? [2015, January 25].